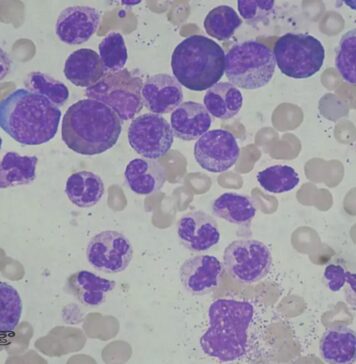
ల్యూకోసైటోసిస్ అంటే ఏమిటీ? కారణాలు, లక్షణాలు, చికిత్స Leukocytosis_ causes, Symptoms & Treatment

కటుక రోహిణి: ప్రయోజనాలు, మోతాదు, దుష్ప్రభావాలు - Katuka Rohini- Health Benefits, Dose,...
కటుక రోహిణి - పిక్రోరిజా కుర్రోవా అనేది రైజోమ్ల ఉనికి కలిగిన శాశ్వత మూలిక యొక్క చేదు వేరు, ఇది ప్రధానంగా దీర్ఘకాలిక జ్వరం, చర్మ రుగ్మతలు మరియు మధుమేహం చికిత్సలో ఉపయోగించబడుతుంది....
నిలబడినప్పుడు మోకాలు ఎందుకు నొప్పి వేస్తుంది? చికిత్స - Stand-Up Struggle: Causes of...
కీళ్ల అరుగుదల వయస్సు పైబడిన పెద్దలలో సహజంగా ఉంటుంది. సంవత్సరాలుగా మోకాళ్లపై మన శరీర భారం అంతా మోపి నడవటం వల్ల వృధ్ధాప్యానికి వచ్చే సరికి వీటిలో అరుగుదల కారణంగా చాలా నష్టం...
డి క్వెర్వైన్ వ్యాధి: కారణాలు, రోగ నిర్ధారణ మరియు చికిత్స - DeQvervains disease:...
డిక్వెర్వైన్ యొక్క టెనోసైనోవైటిస్, తరచుగా డి క్వెర్వైన్స్ వ్యాధిగా సూచిస్తారు, ఇది మీ మణికట్టు యొక్క బొటనవేలు వైపు స్నాయువులను ప్రభావితం చేసే ఒక పరిస్థితి. ఇది సాధారణంగా నొప్పి, వాపు మరియు...
పాలీఫెనాల్స్ అంటే ఏమిటీ.? ఇవి ఎందుకు మంచివి? - Polyphenols: Natural Compounds for...
పాలీఫెనాల్స్ అనేది మొక్కలలో సహజంగా లభించే రసాయనం. మొక్కలలో సహజంగా లభించే సమ్మేళనాల విభిన్న సమూహం అయిన పాలీఫెనాల్స్, వాటి శక్తివంతమైన యాంటీఆక్సిడెంట్ మరియు యాంటీ ఇన్ఫ్లమేటరీ లక్షణాల కారణంగా ఆరోగ్య ప్రయోజనాల...
ఆర్థరైటిస్ రోగులు తీసుకోవాల్సిన యాంటీ ఇన్ఫ్లమేటరీ డైట్ - Anti-Inflammatory Diet for Arthritis...
వయస్సు పెరుగుతున్న కొద్దీ సంక్రమించే అర్థరైటిస్ నొప్పులు, వావుల బాధ వర్ణణాతీతం. కాలు లేదా కీళ్లు కదపాలంటే కూడా చాలా బాధపడుతుంటారు. వీరితో పాటు అర్థరైటిస్ బాధను అనుభవించే బాధితులు కూడా తాను...
రేడియల్ టన్నెల్ సిండ్రోమ్ అంటే ఏమిటీ.? చికిత్స ఎలా.? - Radial Tunnel Syndrome:...
మోచేతి నోప్పి వస్తోందా.? చెయ్యంతా లాగేసినట్టుగా ఉందా.? మోచేతికి ఏది తగిలినా.. తీవ్రమైన నోప్పిగా ఉందా.? ఎన్ని మాత్రలు వాడినా లాభం కనిపించడం లేదా.? చేతి లోపల నుంచి ఏదో నరం లాగేసినట్టుగా...
భుజాల బ్లేడ్ల మధ్య వెన్నునొప్పికి కారణమేమిటి? - What Causes Back Pain Between...
భుజం బ్లేడ్ల మధ్య వెన్నునొప్పి అనేది చాలా మందిని ప్రభావితం చేసే ఒక సాధారణ పరిస్థితి. ఈ రకమైన నొప్పి తేలికపాటి నుండి తీవ్రమైన వరకు ఉంటుంది. ఇది వివిధ కారణాల వల్ల...
వాపుతో పోరాడే విటమిన్లు, సప్లిమెంట్లు ఇవే.! - Vitamins And Supplements That Fight...
వాపు అనేది శరీరం ఇన్ఫెక్షన్లతో పోరాడటానికి మరియు గాయాలను నయం చేయడానికి సహాయపడే సహజమైన మరియు అవసరమైన రోగనిరోధక ప్రతిస్పందన. అయితే, వాపు దీర్ఘకాలికంగా మారినప్పుడు, మాత్రం ఇది కణజాలాలను మరియు అవయవాలను...
కార్పల్, క్యూబిటల్ టన్నెల్ సిండ్రోమ్ అంటే ఏమిటీ.? వాటి మధ్య తేడా.? - Carpal...
మనిషికి మెడ నుండి చేతి వరకు ఉండేది ఉల్నార్ అనే నాడి. ఇది కండరాలను నియంత్రించడంలో సహాయపడుతుంది. ముంజేయి, చేతి మరియు వేళ్లలో సంచలనాల అనుభూతి చెందుతుంది. దానినే క్యూబిటల్ టన్నెల్ సిండ్రోమ్...
సయాటికా నొప్పి: లక్షణాలు, కారకాలు, చికిత్స, నివారణ - Sciatica: Symptoms, Causes, Treatment...
సయాటికా అనేది సయాటిక్ నరాల మార్గంలో ప్రయాణించే నొప్పిని సూచిస్తుంది. సయాటిక్ నాడి పిరుదుల నుండి మరియు ప్రతి కాలు క్రిందికి ప్రయాణిస్తుంది. లావుగా ఉన్నవారు, ఒబెసిటీతో బాధపడే వారితో పాటు వయో...